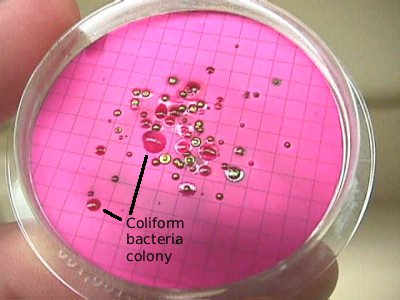
ree

GESONDHEIDSWAARSKUWING – FRANKFORT WATER ONVEILIG
- MBF

- Mar 4, 2024
- 2 min read
Nadat verskeie klagtes en gerugte ontvang is vanaf Frankfort inwoners wie gesondheidsproleme ervaar het wat moontlik toegeskryf kan word aan besmette munisipale water, het Mafube Besigheidsforum (MBF) monsters geneem by punte in Frankfort en gestuur na ‘n geakkrediteerde laboratorium vir ontleding.
Foto: https://water.mecc.edu/
Watermonsters: Alhoewel daar geen E. coli in die monsters opgespoor was nie, toon die mikrobiese analise dat die verskafde monster wat in die sentrale gebied van Frankfort geneem was, 'n groot aantal bakterieë bevat soos aangedui deur die hoë heterotrofiese plaattelling, sowel as hoë totale koliforme bakterieë en dus nie voldoen aan die SANS 241-drinkwater gehalte limiete nie. Die kolivorm bakterieë is 'n gesondheidsrisiko omdat dit patogene bakterieë kan bevat*.
Noodoplossing: Inwoners word hiermee gewaarsku dat munisipale water nie geskik is vir huishoudelike gebruik nie en nie gedrink of gebruik moet word vir voedselvoorbereiding nie, alvorens dit gekook is of met ‘n spesifieke hoeveelheid bleikmiddel behandel is nie.
Warm water: MBF wil ook waasku dat die watertemperatuur van huishoudelike warmwatersilinders (”geysers”) teen hoër as 55 ⁰C gehandhaaf moet word om bakteriëgroei te verhoed. Hierdie is die minimum termostaat temperatuurverstelling maar in die praktyk skakel baie inwoners hul “geysers” af om krag te bespaar, wat ‘n risiko inhou en vermy moet word.
MPM dra kennis, reeds vanaf Des 2023: MBF het so onlangs as Desember 2023 gewaarsku dat die kwaliteit van munisipale water in die Mafube-gebied nie op standaard is nie, toe die Bloudruppel verslag deur die Departement van Water en Sanitasie (DWS) bekendgestel is. Mafube Plaaslike Munisipaliteit (MPM) het volgens dié verslag slegs 4.25% behaal in die assessering – die swakste resultaat in die hele Vrystaat, indien nie die hele land nie.
Die risikobepaling by die Frankfort watersuiwerings aanleg wat Frankfort, Namahadi en Cornelia bedien is 98.1%. DWS het aangedui dat hulle “neem kennis van die haglike toestand van bestuur en drinkwaterkwaliteit in die Frankfort, Tweeling en Villiers watervoorsieningstelsels.”
Wag nog vir oplossing: Die Munisipale Bestuurder was aangesê om 'n gedetailleerde regstelling-aksieplan binne 20 dae na publikasie van die verslag in te dien. Die plan moet die aktiwiteite, verantwoordelike persone, tydlyne en verwagte verbetering aandui. Daar bestaan twyfel of Adv. Lepheana, die waarnemende Munisipale Bestuurder van Mafube, daarop ag geslaan het.
*Toetsresultate is beskikbaar op aanvraag.
MBF nooi inwoners, sake-eienaars en belastingbetalers uit om ons kantore by Kerkstraat 18A, Frankfort op Maandae tot Donderdae van 08h30 tot 16h00 en Vrydae 08h00 tot 12h00 te besoek. Bel of stuur 'n WhatsApp-boodskap aan Marina by 079 145 4295. Besoek ons webwerf www.mafubebf.org en volg ons op Facebook.

Comments